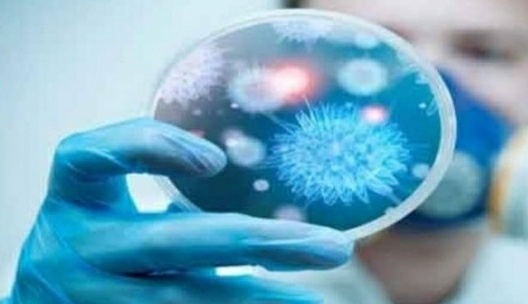
تحضّروا لأنظمة جديدة بعد

تحضّروا لأنظمة جديدة بعد "الحرب العالمية الثالثة" بقلم:عباس ضاهر
السبت, 21 آذار 2020 الساعة 22:54 | مواقف واراء, زوايا
جهينة نيوز:
لن تكون جائحة كورونا عابرة في العالم. تدلّ كل المعطيات على أن التغييرات تحلّ تدريجياً، سياسياً وإقتصادياً ومجتمعياً. أكدّ الإنفتاح الصيني-الأوروبي المتبادل بين عملاق أصفر يتمدد، وعجوز أوروبي يفتح ذراعيه لتلقي المساعدة الصينية بعد الصفعة الأميركية التي وجّهت له، أنّ الشعوب ستحاسب حكوماتها بعد أزمة كورونا: هل صحّت تحالفاتكم الدولية؟ يبدو أن التقوقع الأميركي أصاب الأوروبيين الذين إلتزموا منازلهم في إيطاليا وفرنسا يراقبون المؤازرة الصينيّة الإنسانية المفتوحة بصدق، في ظل تفرّج واشنطن عليهم، وإنشغال الولايات الأميركية بأزماتها لا غير. بينما سقطت التجربة البريطانيّة في مهدها إزاء معادلة "مناعة القطيع"، التي سيُحاسب البريطانيون حكومتهم على إعتمادها لاحقاً، بإعتبارها أنها إستخفّت بالإنسان، ودفعت بفكرة الدفاع عن البشرية إلى الهاوية.
هل يفرض الأوروبيون توجّهات سياسية جديدة بعدما قطّع فايروس كورونا أوصال قارتهم المتحدة؟ أحبطت الجائحة كلّ الفكرة الأوروبيّة الجامعة، فأبقت عملة اليورو حيّة فقط، لكن من دون جدوى إقتصادية متوقّعة في حال تمدّدت تداعيات كورونا، بعد الحجر والعزل ومنع التنقل والإعتماد على الإكتفاء الذاتي. وهنا يُمكن القول إنّ فكرة العولمة أُصيبت في جوهرها الآن، وستُنسف في حال تمدّدت أزمة الوباء لوقت طويل، وخصوصاً في العامل الإقتصادي، الذي يُصاب بكارثة تفرض تغيير النظم الإقتصادية العالمية حتماً: أولاً، لا عروض ولا طلبات خلال الأزمات، مما يعرّض الشركات الى إنهيارات مالية ضخمة.
ثانياً، تفقد الشعوب قدراتها الشرائية تدريجياً بسبب البطالة التي يفرضها التوقّف عن العمل في معظم القطاعات: سفر، سياحة، خدمات، ملبوسات، عقارات، بورصات، صناعات تقنية.
ثالثاً، تتعدّد الأزمات الماليّة العالمية، كما أظهرت تدابير الأميركيين والكنديين والاوستراليين بشأن التقشف في السحوبات المصرفية وحسم الفوائد، مما يؤكد أن نظمهم الماليّة لن تكون معافاة لوقت طويل.
رابعاً، يعزّز العزل التلقائي الذي تقوم به الشعوب، من إحتضار الإقتصاد العالمي الحالي، بغياب تنقّل وتواصل الناس.
خامساً، يطرح متخصّصون أفكار الإقتصادات المحليّة. لكن هناك إشكاليّة: ماذا عن الدول غير المكتفية ذاتيّا؟ ستقع الكارثة بشأن حاجاتها الضرورية، و خصوصا في المعدات التكنولوجيّة والطبيّة والدواء.
سادساً، في حال تمدّدت المساحة الزمنيّة لحياة كورونا، هل سيبقى الناس في منازلهم؟ فلنفترض ان عمر الأزمة تخطّى اكثر من سنة، وتدحرجت الى كارثة، هل ستصمد الشعوب، خصوصاً في الدول الفقيرة إقتصادياً، كلبنان؟
سابعاَ، تؤكد كل المعطيات أن هناك سيناريوهات عالمية إقتصادية وسياسية جديدة ستولد، تشير اليها انهيارات البورصات، وأسعار النفط، والعقارات.
لذلك يصف البروفسور العربي عماد شعيبي ما يجري بأنه "دمار عالمي" على مستوى الإقتصاد، يفرض إستنفار الأمم كما فعل الأميركيون بعد مواجهة "بيرل هاربر"، أو الروس بعد الرد على هجوم النازيين. ومن هنا يشبّه البروفسور شعيبي المرحلة بأنها "حرب عالمية ثالثة"، يموت فيها النظام الإقتصادي الآن.
لكن ما هي البدائل؟ وهل تحلّ بشكل تلقائي من دون حسابات دولية جديدة؟ كل المعطيات توحي بأن التغيير آتٍ، من دون إتضاح هويته. سيصمد الأقوى ليستمر، لكن المؤكد أنّ الصين التي تفوقت على أزمتها ستكسب مع حلفائها الروس، في قيادة مسار الكارثة العالمية نحو الإنقاذ المؤجّل.
المصدر:النشرة
أخبار ذات صلة
جهينة نيوز:
لن تكون جائحة كورونا عابرة في العالم. تدلّ كل المعطيات على أن التغييرات تحلّ تدريجياً، سياسياً وإقتصادياً ومجتمعياً. أكدّ الإنفتاح الصيني-الأوروبي المتبادل بين عملاق أصفر يتمدد، وعجوز أوروبي يفتح ذراعيه لتلقي المساعدة الصينية بعد الصفعة الأميركية التي وجّهت له، أنّ الشعوب ستحاسب حكوماتها بعد أزمة كورونا: هل صحّت تحالفاتكم الدولية؟ يبدو أن التقوقع الأميركي أصاب الأوروبيين الذين إلتزموا منازلهم في إيطاليا وفرنسا يراقبون المؤازرة الصينيّة الإنسانية المفتوحة بصدق، في ظل تفرّج واشنطن عليهم، وإنشغال الولايات الأميركية بأزماتها لا غير. بينما سقطت التجربة البريطانيّة في مهدها إزاء معادلة "مناعة القطيع"، التي سيُحاسب البريطانيون حكومتهم على إعتمادها لاحقاً، بإعتبارها أنها إستخفّت بالإنسان، ودفعت بفكرة الدفاع عن البشرية إلى الهاوية.
هل يفرض الأوروبيون توجّهات سياسية جديدة بعدما قطّع فايروس كورونا أوصال قارتهم المتحدة؟ أحبطت الجائحة كلّ الفكرة الأوروبيّة الجامعة، فأبقت عملة اليورو حيّة فقط، لكن من دون جدوى إقتصادية متوقّعة في حال تمدّدت تداعيات كورونا، بعد الحجر والعزل ومنع التنقل والإعتماد على الإكتفاء الذاتي. وهنا يُمكن القول إنّ فكرة العولمة أُصيبت في جوهرها الآن، وستُنسف في حال تمدّدت أزمة الوباء لوقت طويل، وخصوصاً في العامل الإقتصادي، الذي يُصاب بكارثة تفرض تغيير النظم الإقتصادية العالمية حتماً: أولاً، لا عروض ولا طلبات خلال الأزمات، مما يعرّض الشركات الى إنهيارات مالية ضخمة.
ثانياً، تفقد الشعوب قدراتها الشرائية تدريجياً بسبب البطالة التي يفرضها التوقّف عن العمل في معظم القطاعات: سفر، سياحة، خدمات، ملبوسات، عقارات، بورصات، صناعات تقنية.
ثالثاً، تتعدّد الأزمات الماليّة العالمية، كما أظهرت تدابير الأميركيين والكنديين والاوستراليين بشأن التقشف في السحوبات المصرفية وحسم الفوائد، مما يؤكد أن نظمهم الماليّة لن تكون معافاة لوقت طويل.
رابعاً، يعزّز العزل التلقائي الذي تقوم به الشعوب، من إحتضار الإقتصاد العالمي الحالي، بغياب تنقّل وتواصل الناس.
خامساً، يطرح متخصّصون أفكار الإقتصادات المحليّة. لكن هناك إشكاليّة: ماذا عن الدول غير المكتفية ذاتيّا؟ ستقع الكارثة بشأن حاجاتها الضرورية، و خصوصا في المعدات التكنولوجيّة والطبيّة والدواء.
سادساً، في حال تمدّدت المساحة الزمنيّة لحياة كورونا، هل سيبقى الناس في منازلهم؟ فلنفترض ان عمر الأزمة تخطّى اكثر من سنة، وتدحرجت الى كارثة، هل ستصمد الشعوب، خصوصاً في الدول الفقيرة إقتصادياً، كلبنان؟
سابعاَ، تؤكد كل المعطيات أن هناك سيناريوهات عالمية إقتصادية وسياسية جديدة ستولد، تشير اليها انهيارات البورصات، وأسعار النفط، والعقارات.
لذلك يصف البروفسور العربي عماد شعيبي ما يجري بأنه "دمار عالمي" على مستوى الإقتصاد، يفرض إستنفار الأمم كما فعل الأميركيون بعد مواجهة "بيرل هاربر"، أو الروس بعد الرد على هجوم النازيين. ومن هنا يشبّه البروفسور شعيبي المرحلة بأنها "حرب عالمية ثالثة"، يموت فيها النظام الإقتصادي الآن.
لكن ما هي البدائل؟ وهل تحلّ بشكل تلقائي من دون حسابات دولية جديدة؟ كل المعطيات توحي بأن التغيير آتٍ، من دون إتضاح هويته. سيصمد الأقوى ليستمر، لكن المؤكد أنّ الصين التي تفوقت على أزمتها ستكسب مع حلفائها الروس، في قيادة مسار الكارثة العالمية نحو الإنقاذ المؤجّل.
المصدر:النشرة
اقرأ المزيد...

 الدور الوظيفي للسلطة السورية في معادلات الصراع الجديدة بالشرق الأوسط
الدور الوظيفي للسلطة السورية في معادلات الصراع الجديدة بالشرق الأوسط  وفيق صفا... الصندوق الأسود الذي أصبح عبئاً على حزب الله
وفيق صفا... الصندوق الأسود الذي أصبح عبئاً على حزب الله  بين شهادات الدكتوراه وورقة محروقة: من يحاول تشويه صورة الساحل السوري؟؟
بين شهادات الدكتوراه وورقة محروقة: من يحاول تشويه صورة الساحل السوري؟؟  قبيل أيام من انتهاء مهلته... ما مصير اتفاق مارس بين الحكومة السورية وقسد؟
قبيل أيام من انتهاء مهلته... ما مصير اتفاق مارس بين الحكومة السورية وقسد؟  حلّ الجيش السوري.. سيناريو عراقي مجرَّب... بقلم: ليلى نقولا _ أستاذة العلاقات الدولية في الجامعة اللبنانية
حلّ الجيش السوري.. سيناريو عراقي مجرَّب... بقلم: ليلى نقولا _ أستاذة العلاقات الدولية في الجامعة اللبنانية  حول آخر التطورات في شمال سورية.. بقلم نارام سرجون
حول آخر التطورات في شمال سورية.. بقلم نارام سرجون  نَعَمْ نَصْرٌ مرٌّ - بقلم النائب محمد رعد
نَعَمْ نَصْرٌ مرٌّ - بقلم النائب محمد رعد  ضمانة حفظ السيادة.. معادلة الشعب والجيش والمُقاومة - بقلم النائب محمد رعد
ضمانة حفظ السيادة.. معادلة الشعب والجيش والمُقاومة - بقلم النائب محمد رعد  كوبا: دروس مستفادة -بقلم: أ.د بثينة شعبان
كوبا: دروس مستفادة -بقلم: أ.د بثينة شعبان  محمد بن سلمان لبلينكن: لا لاتفاق سلام مع إسرائيل… نعم للاستثمار في سوريا في مقابلته الأخيرة مع قناة سي ان ان الأميركية
محمد بن سلمان لبلينكن: لا لاتفاق سلام مع إسرائيل… نعم للاستثمار في سوريا في مقابلته الأخيرة مع قناة سي ان ان الأميركية  من الفقر العام إلى الفقر المدقع: درَك جديد في الهاوية السورية. بقلم: زياد غصن
من الفقر العام إلى الفقر المدقع: درَك جديد في الهاوية السورية. بقلم: زياد غصن  في حضرة الرئيس الأسد.. حوار سياسي يضع الإعلاميين في عمق الموقف
في حضرة الرئيس الأسد.. حوار سياسي يضع الإعلاميين في عمق الموقف  قاسم سليماني.. الشاهد والشهيد.. بقلم/ د. وليد القططي
قاسم سليماني.. الشاهد والشهيد.. بقلم/ د. وليد القططي  إليزابيث.. الموت في لندن والحِداد في عمّان بقلم الدكتور وليد القططي
إليزابيث.. الموت في لندن والحِداد في عمّان بقلم الدكتور وليد القططي  لقاء عباس-بايدن.. سيرٌ عكس نداء الوطن
لقاء عباس-بايدن.. سيرٌ عكس نداء الوطن  الجيش الإيراني يستهدف مقر هيئة أركان الحرب للكيان الصهيوني والحرس الثوري يسقط مسيّرة من نوع MQ9
الجيش الإيراني يستهدف مقر هيئة أركان الحرب للكيان الصهيوني والحرس الثوري يسقط مسيّرة من نوع MQ9
 معركة العصف المأكول.. سلسلة عمليات لحزب الله تستهدف المستوطنات وتجمعات للاحتلال
معركة العصف المأكول.. سلسلة عمليات لحزب الله تستهدف المستوطنات وتجمعات للاحتلال
 مقتل عدد من الأشخاص في انفجار لذخائر وصواريخ في حمص وريف حلب
مقتل عدد من الأشخاص في انفجار لذخائر وصواريخ في حمص وريف حلب
 أستون فيلا الإنكليزي يتغلب على مضيفه ليل الفرنسي في ثمن نهائي الدوري الأوروبي
أستون فيلا الإنكليزي يتغلب على مضيفه ليل الفرنسي في ثمن نهائي الدوري الأوروبي
 وزارة التربية: إيقاف الامتحان المتمم لمعادلة الشهادات الأجنبية للطلاب السوريين لعامين
وزارة التربية: إيقاف الامتحان المتمم لمعادلة الشهادات الأجنبية للطلاب السوريين لعامين
